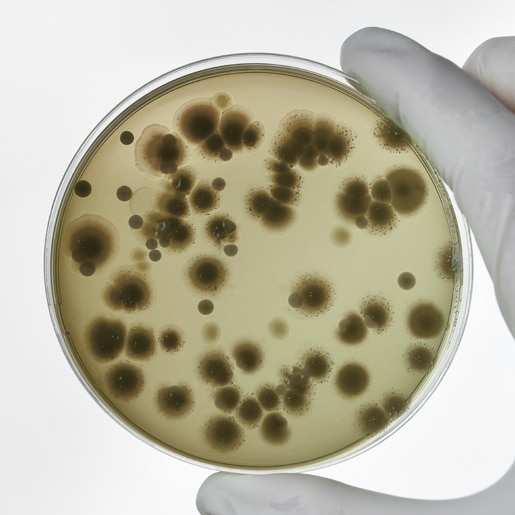

The BD Aptra™ Single-Use Digital Flexible Cystoscope is a versatile solution crafted with both patients and providers in mind, ergonomically designed to bring visibility to urology procedures. The digital cystoscope system is intended to be used by physicians to access, visualize, and perform procedures in the bladder and lower ureter. The instrument enables delivery and use of accessories such as biopsy forceps, laser fibers, graspers, and retrieval baskets at a surgical site. The cystoscope captures real-time images and transmits them to BD Aptra™ Image System for processing.
BD Aptra™ Single-Use Digital Flexible Cystoscope
The visualization tool used to start a urological procedure


- Overview
- Why Choose Single-Use?
- Products & Accessories
- EIFU & Resources
Specially engineered tip
- 6.6 Fr. working channel
- Camera module and two LEDs built into a tapered 9 Fr. distal tip
- Image quality enhanced by LEDs in the tip
- Smaller average distal tip and outer diameter than the Ambu® aScopeTM Cystoscope*

Designed for a greater maximum deflection angle
- Maximum deflection of 210° in two directions with passive hold bending
- 90° more deflection in the down direction than the Ambu® aScope™ Cystoscope+
Handle Functionality
- Ergonomic handle design & optimized location of access port and power cord for easier handling.
- Two programmable buttons to control key functionalities (e.g. brightness, zoom) and up to 3 unique user profiles can be stored on the BD Aptra™ Image System.
*Based on bench-top testing. May not be indicative of actual clinical performance.
†Information for Ambu® aScope™ 5 excerpted from literature published by Ambu
Indications, Contraindications, Warnings
Intended Use:
BD Aptra™ Digital Cystoscope System is intended to be used by physicians to access, visualize, and perform procedures in the bladder and lower ureter. The instrument enables delivery and use of accessories such as biopsy forceps, laser fibers, graspers, and retrieval baskets at a surgical site.
Contraindications:
Diagnostic or therapeutic endoscopy is contraindicated in people with an untreated urinary tract infection. Other contraindications to therapeutic endoscopy (e.g. lithotripsy, endopyelotomy, tumor therapy) are more numerous and can mirror those associated with the corresponding open surgical interventions. Patients on anticoagulants or with coagulopathies should be managed appropriately.
Warnings:
- Do not use electromedical energy sources in the presence of flammable detergents, anesthetics, nitrous oxide(N20), or oxygen.
- Consult the user manuals of all electromedical energy sources used with endoscopic instruments for appropriate instruments, warnings, and cautions prior to use. Such sources of energy include electrical, electrohydraulic, electrosurgical, heat hydraulic, laser, light, pressure, sound, ultrasound, and vacuum.
- Do not insert or advance the cystoscope unless there is a clear live endoscopic view of the lumen through which the scope is being advanced(or confirm with visualization by other imaging modalities).
- During the procedure, if the live endoscopic image is lost, do not advance or insert the cystoscope and do not insert, advance or actuate accessories.
- Do not use excessive force while advancing or withdrawing the scope. If resistance is felt during advancement or withdrawal of the scope, investigate the source of resistance and/or take remedial action if necessary.
- Do not force the distal tip of the cystoscope against the sidewall of the bladder or urethra.
- Do not use excessive force when advancing or withdrawing an accessory within the cystoscope.
- When inserting or using accessories, maintain continuous visualization of the distal tip. Ensure that the distance between the distal tip of the cystoscope and the object in view is greater than the cystoscope’s minimum visible distance. Failure to do so may result in the accessories causing patient injury.
- Do not withdraw a laser fiber back into the cystoscope while the laser is firing. Doing so may cause patient injury and/or scope damage.
- Do not look directly into the light emitted from the cystoscope.
- Verify ground isolation when setting up and using accessories from different manufacturers prior to procedure.
- Do not open the handle of the cystoscope.
- The cystoscope is a single-use device and there are no serviceable parts. Do not repair damaged or non-operating cystoscopes. Do not use the cystoscope if damage is discovered or suspected.
- Do not excessively bend the flexible shaft or the articulating section of the cystoscope.
- If damage to the cystoscope occurs or it stops functioning during a procedure, stop using the cystoscope immediately. See troubleshooting section for more information. Continue the procedure with a new cystoscope, as appropriate.
- Inflow of gas e.g. supplied by endoscopic accessories or due to over-insufflation of gas may cause gas embolism, leading to stroke or ischemia in tissue.
Reduced risk of infection
Patients who had cystoscopy with a disposable cystoscope were associated with a lower number of post-procedural encounters and positive urine cultures.1
3.1% of patients reported UTIs after cystoscopy for stent removal with a reusable scope compared to 0% of patients reporting infection after a cystoscopy with single use.2

Better patient experience
Flexible diagnostic cystoscopy caused less pain than rigid cystoscopy.3

Savings with reprocessing
Total reprocessing time saved per scope for single-use cystoscope users is 42 minutes and 1 second, excluding pre-cleaning.4

Optimized case efficiency
The average labor time spent per case with single-use scopes was 10 minutes, compared with 32 minutes with reusable cystoscopes.5
Single-use cystoscopes significantly reduced hands-on labor time for pre- and post-procedure compared to reusable cystoscopes[MT1] .4
- Geldmaker, L.E.; Baird, B.A.; et al. Conversion to Disposable Cystoscopes Decreased Post-Procedure Encounters and Infections Compared to Reusable Cystoscopes. American Urological Association Journal. 2023; 10: 311-318.
- Alkhamees, M.; Alothman, A.; et al. Reusable vs. single-use cystoscope for removal of double-J stent: a prospective randomized comparison and cost analysis. Eur Rev Med Pharmacol Sci. 2022; 26: 4628-4273.
- Seklehner, S.; Remzi, M.; et al. Prospective Multi-institutional Study Analyzing Pain Perception of Flexible and Rigid Cystoscopy in Men. Urology. 2015; 85: 737-741.
- Haislip, I.; Rindorf, D.; et al. Workfl ow effi ciencies for fl exible cystoscopy: comparing single-use vs reusable cystoscopes. BMC Urol. 2024; 24: 53.
- Young, J.A.; Garden, E.B.; et al. Journal Briefs: The Journal of Urology: Disposable versus Reusable Cystoscopes - A Micro-Costing Value Anaylsis in High-Volume and Low-Volume Urology Practices. Journal of Urology. 2021; 8: 466.
Lorem ipsum dolor sit amet, consectetur adipiscing elit, sed do eiusmod tempor incididunt ut labore


